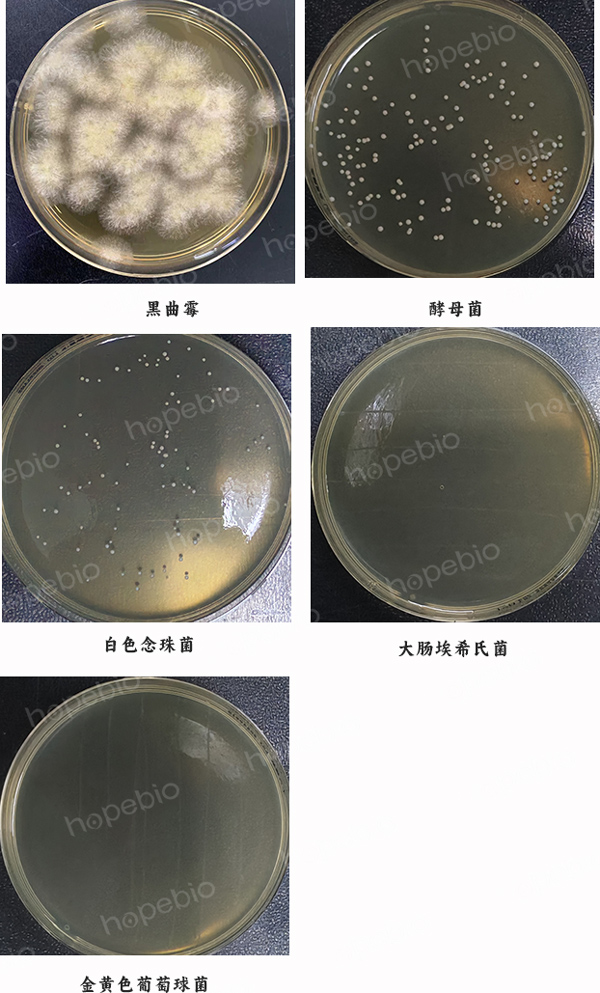

海博微信公众号
海博微信公众号
 海博天猫旗舰店
海博天猫旗舰店


 海博微信公众号
海博微信公众号
 海博天猫旗舰店
海博天猫旗舰店




一、培养基的用途及原理
氯霉素对革兰氏阳性、阴性细菌均有抑制作用且对后者的作用较强。常用于真菌的选择性分离,抑菌细菌的生长发育。
二、成分(g/L)
|
马铃薯粉 |
6.0 |
|
葡萄糖 |
20.0 |
|
氯霉素 |
0.1 |
|
琼脂 |
20.0 |
三、配制方法
称取本品 46.1g,加入1000ml 蒸馏水中,121℃高压灭菌 20分钟,备用。灭菌好的培养基仅可重复加热熔化一次。
注:培养基中使用的马铃薯浸粉中含有较多淀粉类成分,灭菌后的培养基稍浑浊,可能出现少量白色沉淀,摇匀倒平板即可。灭菌前加热煮沸溶解培养基再进行灭菌不易出现沉淀。
四、生长现象及结果观察
接种以下质控菌株,在28±1℃下需氧培养48-96小时:
|
质控菌株 |
菌株编号 |
接种量/CFU |
生长现象 |
|
黑曲霉 |
ATCC16404 |
20-200 |
有黑色孢子,白色菌丝 |
|
酿酒酵母 |
ATCC9763 |
20-200 |
奶油色菌落 |
|
白色念珠菌 |
ATCC10231 |
20-200 |
奶油色菌落 |
|
金黄色葡萄球菌 |
ATCC6538 |
/ |
抑制 |
|
大肠埃希氏菌 |
ATCC25922 |
/ |
抑制 |
相关产品:
注:本文刷海博生物原创,未经允许不得转载。
下一篇:没有了!



